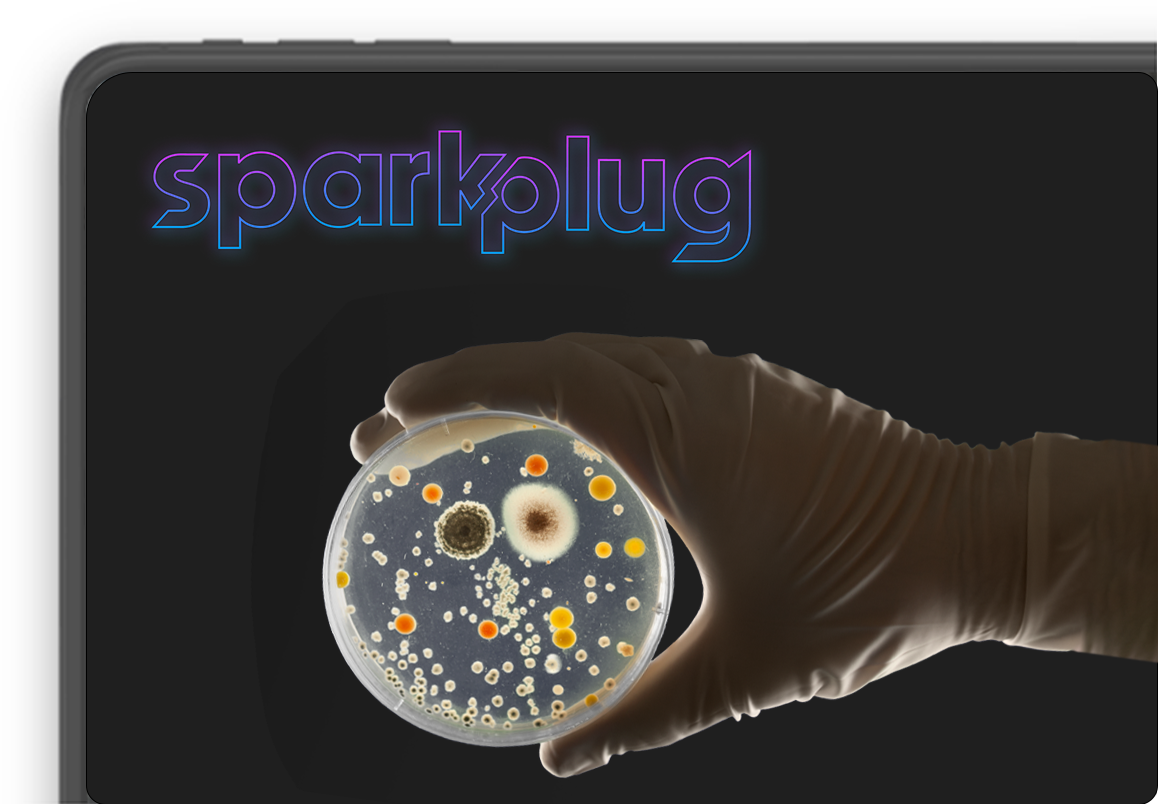
Engineering Life - The Next Frontier in Biotech Innovation

Join us for regular events at the Turbsotart HQ and get access to insightful sessions and an expansive network of leaders and startup founders. Here are some sneak peaks even if you missed it.
Exploration of the exciting and transformative realm of biotechnology...
Read More
Ten outstanding startups will get a chance to take the spotlight, with three exceptional ventures aligned within...
Read More
Relive the electric atmosphere and the exciting moments from our recently concluded Startup Forum- an event designed to bring together...
Read More
Turbostart offers seed and pre-Series A funding to innovative startups, along with personalized mentorship, access to excellence centers, and a vast network for fostering successful enterprises.